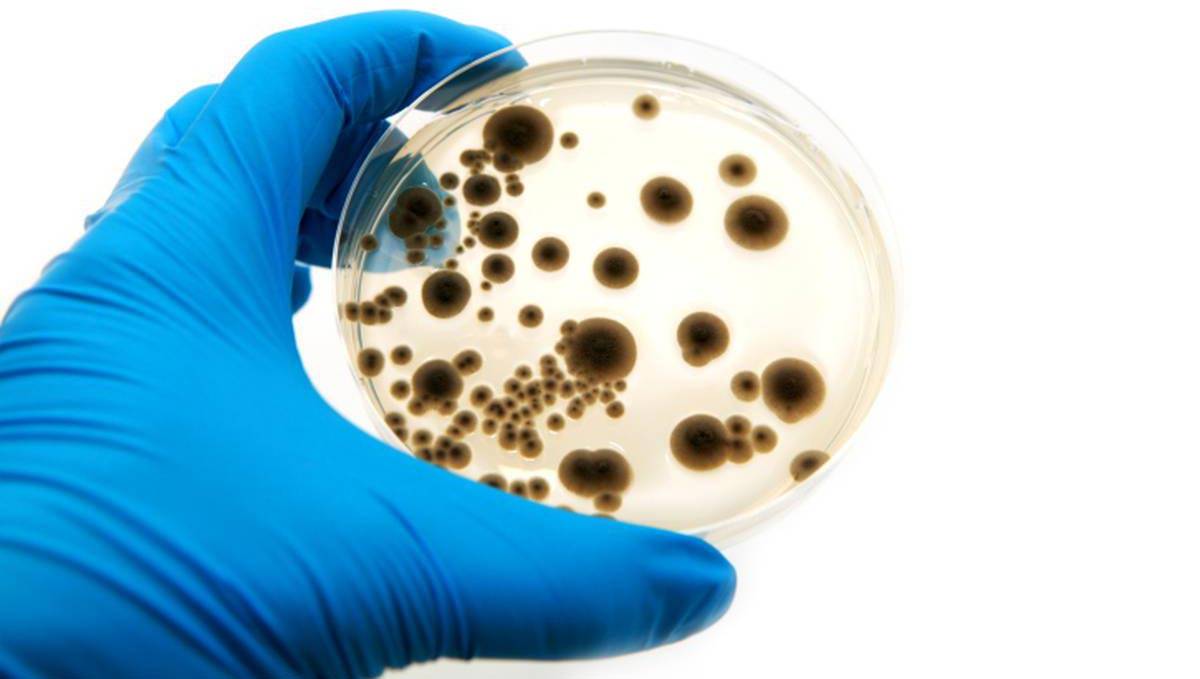

Что такое ячмень на глазу?
Ячмень на глазу – заболевание глазного века, характеризующееся воспалением волосяной луковицы ресницы, сальной железы Цейса или дольки мейбомиевой железы.
Другие названия болезни — гордеолум (hordeolum).
Волосяная луковица и сальная железа Цейса расположены снаружи века, а мейбомиевая железа внутри, в связи с чем, разделяют внешний или внутренний ячмень. Другим вводом из данной информации является то, что правильнее называть эту болезнь — ячмень века, а не глаза, однако для расширения круга читателей, в статье мы будем называть ее ячмень глаза.
Основной симптом ячменя – воспаление и отек века, который по мере развития воспалительного процесса краснеет, увеличивается в размерах, начинает болеть, после образовывается мешочек с гнойным содержимым.
Главным виновником ячменя на веке является золотой стафилококк (около 95% всех случаев заболевания), однако воспаление маловероятно при сильном иммунитете, поэтому развитие болезни обусловлено сочетанием двух вышеперечисленных факторов.
Развитие болезни
Развитие ячменя, как мы уже и говорили, возможно при совокупности двух основных факторов – проникновение под кожу инфекции, в нашем случае стафилококка и ослабленный иммунитет.
Стафилококковая инфекция практически всегда присутствует на поверхности кожного покрова, однако защитные функции организма не позволяют ей распространятся внутрь организма, однако некоторые факторы, которые ослабляют иммунитет все же играют немаловажную роль для развития стафилококковых заболеваний.
Среди основных причин ослабленной иммунной системы можно выделить – стрессы, переохлаждение организма, наличие различных заболеваний, особенно инфекционного характера, недостаточность витаминов (гиповитаминозы).
Конечно, если человек придерживается правил личной гигиены – не трогает грязными руками глаза, лицо, тогда занесение инфекции также минимизируется.
Развитие ячменя. Развитие ячменя начинается с проникновения инфекции в ресничный фолликул, который фактически является «микрокарманом» для реснички, и продвигаясь далее, стафилококк оседает в луковице ресницы, являющимся ее корнем или же небольшом ответвлении – сальной железы Цейса. В случае проникновения инфекции под веко, она может осесть в протоке мейбомиевой железы. Для лучшего понимания локализации болезни, ниже представлено строение века с этими местами (выделены красным шрифтом):
Далее инфекция начинает в этих местах активно размножаться. При этом, развивается воспалительный процесс. Сначала, в месте воспаленной луковички отмирают здоровые клетки, которые начинают гноиться. Место воспаления начинает отекать, краснеть, увеличиваться в размерах, образовывая некоторое твердое уплотнение. Помимо внешних признаков, по мере развития болезни, человек ощущает сильный зуд, а при касании воспаленного участка – боль.
В связи с особенностью локализации потенциально-уязвимых мест образования ячменя, припухлость и гнойнички появляются только на краях верхнего или нижнего века.
Образование гнойника обычно происходит на 2-4 день после инфицирования века. На этом этапе также краснеет конъюнктива. На уплотнении образовывается небольшой шарик с желтоватым гнойным содержимым. На одном веке также может образовываться более одного гнойника.
Полное созревание ячменя происходит за 3-7 дней.
Сильной инфицирование на фоне ослабленного иммунитета может дополнительно вызвать повышение температуры тела до 38 °С, тошноту и другие признаки интоксикации организма.
После полного созревания, обычно на 3-4й день, под давлением гнойных масс, гнойник обычно прорывается, гной вместе с омертвевшими тканями выходит наружу, после чего боль проходит и ячмень на веке самостоятельно рассасывается, однако если ячмень не проходит более одной недели, обратитесь к офтальмологу. После самопроизвольного вскрытия гнойника, припухлость быстро спадает, и буквально на следующий день, на этом остается легкая отечность, однако покраснение века остается еще на пару дней.
Иногда гнойник самовольно не вскрывается, и ячмень при этом самовольно рассасывается, но бывают случаи, когда обычная форма болезни превращается в так называемый – холодный ячмень (халязион). Характерной особенностью халязиона является длительное развитие и течение воспалительного процесса, непреходящего около 1-2 месяцев. В некоторых случаях, если халязион самостоятельно не проходит, он требует удаления хирургическим путем.
Симптомы ячменя
Воспалительный процесс обычно развивается довольно быстро. Ячмень — это не то состояние, которое долгое время может протекать бессимптомно.
С первых дней воспаление сопровождается отеком век, жжением и зудом. У некоторых людей мигание становится более учащенным. В тяжелых случаях на месте гордеолума возникает очень сильный отек, из-за которого человеку сложно открыть глаза по утрам. Основные признаки ячменя — это:
- покраснение и отек век;
- склеивание и выпадение ресниц;
- ощущение в глазу инородного тела;
- уплотнение краев век;
- светочувствительность.
У некоторых людей во время образования гордеолума повышается температура. Они быстро устают, чувствуют недомогание, слабость. При надавливании на очаг возникают болезненные ощущения. Начальные стадии воспаления часто сопровождает головная боль, давление в висках. При тяжелых формах ячменя, которые возникают во время ОРВИ или на фоне конъюнктивита, в уголках глаз может скапливаться пенистое содержимое.
Лечение дома – можно ли греть?
Две процедуры, наиболее часто практикуемые в домашних условиях, – промывания и прогревания, – также нуждаются в важных уточнениях. Для симптоматического облегчения дискомфортных ощущений самостоятельно промывать пораженный глаз можно только травяными отварами асептического действия (ромашка, календула, обычный чай и т.д.), причем о составе сбора и тактике его применения крайне желательно посоветоваться хотя бы с провизором в аптеке.
Что касается прогревания, то с определенного момента оно может быть достаточно эффективным средством сокращения общей продолжительности заболевания, но на начальном этапе гордеолума тепло категорически противопоказано – и именно поэтому, опять же, не стоит рисковать здоровьем и жизнью: любые прогревания должны назначаться и контролироваться врачом. В амбулаторных поликлинических условиях с этой целью могут применяться физиотерапевтические процедуры (напр., всем известное УФО или УВЧ-прогревание).
Кроме того, строго противопоказано использование каких бы то ни было гримирующих веществ и составов для маскировки косметического дефекта – какой бы психологический дискомфорт он ни доставлял, риск и потенциальный ущерб от такого макияжа намного выше.
Профилактика ячменя у детей
Некоторых офтальмологических болезней невозможно избежать, какой бы серьезной ни была профилактика.
Важно! Ячмень – не исключение, но прямой профилактики этого заболевания не существует: можно лишь косвенно добиться того, чтобы такой вид воспалений возникал у ребенка как можно реже.
Для этого необходимо поддерживать детскую иммунную систему и обеспечить детям правильный рацион питания: при наличии в пище всех необходимых витаминов и микроэлементов детский сильный организм сам сформирует иммунитет.
Важно научить ребенка основным правилам личной и общей гигиены, чтобы минимизировать риск заражения
Как лечить ячмень?
В большинстве случаев ячмень проходит самостоятельно в течение нескольких дней или недель. Однако с помощью лечения можно ускорить этот процесс и облегчить симптомы. Самое главное, никогда не пытайтесь выдавить гной из ячменя. Такое самолечение может привести к опасным для жизни осложнениям.
Лечение ячменя в домашних условиях
На начальных стадиях ячменя можно обрабатывать кожу в месте припухлости ватной палочкой, смоченной в растворе бриллиантовой зелени (зеленки), спиртовой настойке йода или медицинском спирте
Следует соблюдать осторожность, чтобы не повредить слизистую глаза
На стадии созревания ячменя применяют сухое тепло, прогревая веко с помощью чистого мешочка с разогретым рисом, семенами льна, солью или песком. Эти наполнители долго держат тепло. Врач может назначить специальные физиопроцедуры, которые помогут ускорить созревание ячменя и уменьшат боль.
Не рекомендуется применять влажные компрессы, так как это способствует распространению инфекции на соседние железы и волосяные луковицы века и может ухудшить состояние. При вскрытии гнойника необходимо следить за чистотой и гигиеной в области глаз. Очистить глаз от отделяемого можно с помощью стерильных марлевых салфеток, смоченных в кипяченой воде. Не используйте одну и ту же салфетку для обоих глаз — так можно перенести инфекцию.
Лечение ячменя с помощью лекарств и операции
Если ячмень причиняет сильную боль, можно принимать обезболивающие, такие как парацетамол или ибупрофен. Они продаются в аптеках без рецепта. Всегда читайте инструкцию по применению средства. В ней содержится информация о противопоказаниях и дозировке. Детям младше 16 лет не следует давать аспирин.
Для профилактики гнойных осложнений и конъюнктивита, а также для ускорения выздоровления врач может рекомендовать использование глазных капель и мазей, которые содержат антибиотики. В случае выраженных общих симптомов: повышения температуры, увеличения лимфатических узлов, слабости, интоксикации назначается антибиотикотерапия в таблетках.
Какие болезни провоцируют развитие гордеолума?
Считается, что основная причина возникновения ячменя — переохлаждение организма и связанные с ним простудные заболевания. Воспалительный процесс часто развивается из-за ослабленного иммунитета, который не может бороться с бактериями и вирусами. К патологиям бактериальной и вирусной природы, которые становятся причиной воспаления, являются такие болезни, как:
- синусит;
- этмоидит;
- тонзиллит;
- сфеноидит;
- фронтит.

Ячмень — это одно из распространенных следствий многих хронических заболеваний. Они приводят не только к возникновению воспаления, но и усложняют его диагностику и лечение. При некоторых болезнях навсегда избавиться от ячменя очень трудно, так как они предрасполагают к рецидивам воспалительного процесса. К таким патологиям относятся:
- анемия;
- гастрит;
- сахарный диабет;
- язвенная болезнь желудка;
- гиперлипидиемия;
- перитонит;
- фурункулез.
Организм регулярно должен получать количество витаминов, которое требуется для его нормальной работы. Развитие воспалительного процесса часто бывает связано с дефицитом витаминов групп А, В и С.
Иногда ячмень возникает из-за нарушений, которые по мнению многих людей не представляют опасности для здоровья. Например: гельминтоз, склонность кожи к сальности, образование угревой сыпи.
Лечение ячменя и халязиона
Чаще всего ячмень и халязион способны проходить самостоятельно. Ячмень сам вскрывается с выходом гноя через 3-4 дня, а халязион рассасывается в течение 1-6 месяцев.

Вполне реально ускорить эти процессы и уменьшить болевые ощущения, например, помогут тёплые компрессы по 5-10 минут 2-4 раза в день, очищение края век с помощью раствора детского шампуня.
Ускорить созревание ячменя может помочь удаление ресницы в очаге воспаления, а при халязионе можно попробовать лёгкий массаж после тёплого компресса.
Если у вас конъюнктивит или блефарит, то врач назначит вам антибактериальные капли или мази.
Бывают случаи, когда консервативная терапия не помогает, либо размеры ячменя или халязиона слишком большие, тогда возможно разрешение с помощью хирургического лечения – врач вскрывает/дренирует ячменя, удаляет халязион или делает инъекцию кеналога в халязион.

Если ячмень – частый гость, то вылечиться только с помощью местных средств, например, антибактериальными мазями, невозможно. Следовательно, потребуется приём препаратов внутрь, как правило антибиотиков. Исходя из того, что причиной ячменя является стафилококк, то врач назначит антибиотики, которые хорошо справляются именно с этой бактерией. Также стоит отметить, что лечение кожных инфекций редко заканчивается через 5-7 дней, то есть препараты придётся принимать минимум 14 дней.
Что неэффективно?
В первую очередь здесь нужно сказать о том, выдавливать ячмень категорически запрещается! Дело в том, что механическое воздействие в данном случае приведёт к распространению инфекции и ситуация ухудшится в разы.
Также неэффективны любые народные средства, которые могут усугубить течение болезни, что приведёт к более длительному лечению. И аргументы из разряда «но мне же помогло» не работают, потому что «после» – не значит «вследствие».
Чем лечить ячмень на глазу
У многих людей заболевание проходит в легкой форме и не требует обращения к врачу. Если же сильно выражены отек и гиперемия (покраснение), необходимо обязательно обратиться в клинику. Чем лечить гордеолум в каждом конкретном случае, должен решать специалист. При внутреннем ячмене может понадобиться хирургическое вмешательство. Сколько проходит заболевание, зависит от степени воспаления.
Лечение ячменя. Фото: michaklootwijk / Depositphotos
Консервативная терапия
В основном, лечение заключается в использовании антибактериальной терапии широкого спектра действия. Применяют препараты в форме капель. Они локально и целенаправленно воздействуют на пораженный участок
При наружном ячмене это важно для того чтобы снизить риск развития побочных эффектов в виде дисбаланса естественной микрофлоры конъюнктивальной полости. Антибактериальные мази обладают пролонгированным эффектом, так как длительное время сохраняются на коже и в конъюнктивальной полости
Назначают антибиотики в форме мази — также действующие против большинства возбудителей, которые становятся причиной гордеолума. Перорально антибиотики применяют редко — только при риске генерализации инфекционного процесса.
У отдельных пациентов возможна аллергическая реакция, которая усиливает отек. Таким больным назначают антигистаминные средства.
Чем лечить ячмень
- Тетрациклиновая мазь. Традиционный препарат для лечения ячменя, оказывающий антибактериальное, антисептическое и противовоспалительное действие.
- Мази, основанные на сочетании хлорамфеникола с метилурацилом. Хорошо снимают отек, оказывают бактерицидное действие. Ткани века быстрее восстанавливаются.
- Эритромициновая мазь. Препарат на основе антибиотика, который хорошо справляется со стафилококком, грибками.
- Мазь Вишневского. Лекарство на растительной основе, которое эффективно снимает боль, отек.
- Мази на основе хлорамфеникола — антибиотика широкого спектра действия, который часто назначают при осложнениях ячменя.
- Гидрокортизон. Мазь с противовоспалительным, противоотечным, противозудным действием. Зачастую ее применяют в паре с одним из антибиотиков.
- Офлоксацин — антибиотик последнего поколения группы фторхинолонов, доказал высокую эффективность при лечении гордеолума.
Хирургическое лечение
Операция не относится к сложным. Проводит ее чаще всего офтальмолог. Врач вскрывает гнойную капсулу, следит за тем, чтобы гной полностью вышел. Затем промывает ранку, обрабатывает антисептиком. Дальнейшее лечение заключается в применении одного или нескольких препаратов, описанных выше. В сложных случаях понадобится 1-3 раза посетить врача для промывания и обработки, чтобы избежать рубцевания раны и сохранить эстетичный вид века.
Кандидат медицинских наук Екатерина Яцкевич рассказывает, какие факторы могут спровоцировать ячмень и каковы методы лечения.
Сколько проходит ячмень на веке
Как правило, прогноз благоприятный при условии своевременного обращения к врачу и выполнении всех рекомендаций, касающихся лечения. При слабо выраженных симптомах и сильном иммунитете болезнь проходит за 2-4 дня. При значительном отеке и воспалении лечение может занять 7-10 дней.
Почему нельзя выдавливать ячмень
«Выдавливать ячмень категорически нельзя! Веко находится очень близко к глазу. Если гной выдавится не наружу, а вовнутрь, стафилококк может попасть в кровь, разнестись по всему веку, попасть в глаз. В этом случае может произойти тромбоэмболия центральной артерии сетчатки и человек может ослепнуть», — врач-офтальмолог Дмитрий Дементьев.
В легких клинических случаях возможно самолечение в домашних условиях
Однако важно организовать его правильно и не допускать ошибок, которые могут привести к осложнениям
5 основных ошибок при лечении ячменя
1. Тепловые компрессы вареным яйцом, мешочком с солью/песком только провоцируют развитие инфекции и способствуют прорыву гноя.
2. Ни в коем случае нельзя выдавливать гнойник — можно лишь травмировать ткани, а инфекция распространится с кровью по всему организму.
3. Нельзя прижигать воспаленный участок спиртом, зеленкой, йодом, так как можно случайно травмировать глаз и получить ожог кожи.
4. Нельзя пользоваться косметикой и носить контактные линзы до полного выздоровления.
5. Влажные компрессы (в том числе чайные) могут спровоцировать появление новых очагов воспаления.
Симптомы ячменя на веке глаза
Различают 2 вида ячменя: наружный и внутренний.
Наружный ячмень развивается в результате воспаления цейсовых желез, расположенных в зоне корней ресниц. Эти железы производят специальный секрет для смазки и защиты поверхности глаза. Ячмень на глазу образуется в результате закупоривания железы ее же секретом и появления в этом месте инфекции.
Внутренний ячмень возникает при засорении мейбомиевых сальных желез, находящихся во внутреннем веке. При внутреннем ячмене воспаление может захватывать и хрящевую пластинку века. При частых рецидивах заболевание становится хроническим и может перейти в другое, очень неприятное глазное заболевание – халязион.
Ячмень бывает как одиночным, так и многочисленным, поражающим оба глаза. Многочисленные и часто повторяющиеся ячмени встречаются у людей со слабым иммунитетом (при онкологических заболеваниях, вирусном гепатите, ВИЧ-заболеваниях) или пожилого возраста.
Заболевание ячменем характеризуется острым течением и быстрым развитием патологического процесса. Вначале появляется зуд по краю век, сопровождающийся отечностью и болевым синдромом, который может увеличиться при нажатии на воспаленную зону. Иногда при ячмене настолько сильно отекает глаз, что человек даже не может его открыть.
При появлении многочисленных ячменей на глазу наблюдается повышенная температура, головная боль, озноб и ломота в теле, увеличение лимфатических узлов около ушей и под челюстью.
Через некоторое время на ячмене появляется гнойничок (пустула), и боль начинает стихать. При самостоятельном вскрытии ячменя гнойное содержимое начинает выходить, и признаки заболевания исчезают. Иногда воспаление может продолжаться до 7 дней.
Внутренний ячмень появляется на внутренней стороне века в толще хряща. Если вывернуть веко, можно заметить покраснение и отек конъюнктивы. Через три дня под кожей века появляется гнойный шарик желто-зеленого цвета. Самопроизвольное вскрытие ячменя происходит в области конъюнктивы. Позже в этом месте появляются листовидные грануляции.
Ячмень на веке глаз у ребенка
У детей достаточно слабый иммунитет, поэтому они страдают от ячменя намного чаще, чем взрослые. При этом заболевании возникает гиперемия и отек века, в результате этого глазная щель сужается и ребенку иногда бывает сложно открыть глаз. Появление ячменя на глазу сопровождается ознобом, повышенной температурой, головной болью и резкой болезненностью воспаленного глаза.
Спровоцировать патологию могут следующие факторы: конъюнктивит, желудочно-кишечные заболевания, глистная инвазия, аллергия. Даже переохлаждение или перегрев детского организма могут стать причиной ячменя, не говоря уже о таких заболеваниях, как отит, тонзиллит, аденоиды.
Если не провести лечение ячменя на глазу, у ребенка может сильно пострадать зрение.
При появлении ячменя на глазу нужно как можно быстрее посетить врача-офтальмолога. Он выявит причину заболевания и назначит адекватное лечение.
Не следует самостоятельно выдавливать ячмень! Это может привести к таким осложнениям, как флегмона глазницы, абсцесс на веках, тромбофлебит сосудов орбитальных век, менингит и сепсис!
Классификация ячменя
Обычно ячмень у взрослых и у детей делят на наружный и внутренний — по месту возникновения воспалительного процесса.
Наружный ячмень
Наружный ячмень возникает гораздо чаще, чем его внутренний «собрат». Место локализации — внешняя, видимая поверхность века.
Внешний ячмень появляется из-за инфицирования фолликулов ресниц или желез, которые находятся у края век. От него обычно страдают железа Цейса и железа Молля. Сальные железы Цейса располагаются парно вокруг каждого фолликула, в который и выделяют свой секрет. Потовые железы Молля находятся там же, функция их до сих пор до конца не выяснена.
При наружном ячмене на внешней стороне верхнего или нижнего века образуется нарыв с белым гнойником на верхушке. Со временем гнойник созревает и вскрывается. После этого начинается регенерация тканей: чаще всего в течение нескольких дней от воспаления не остается и следа.

Симптомы наружного ячменя
Обычно заболевание имеет легкое начало: человек может даже не заметить, что со здоровьем возникла проблема. К первичным симптомам ячменя на глазу относят:
- гиперемию века;
- отечность;
- боль, покалывание в пораженном участке;
- слезотечение.;
Через 2−4 дня инфильтрат лопается, гнойное содержимое выходит наружу. После этого боль стихает и начинается процесс заживления.
По симптомам ячмень на верхнем веке ничем не отличается от ячменя на нижнем веке.
Внутренний ячмень
Что касается внутреннего ячменя, зона его поражения — дольки мейбомиевых желез, находящиеся в хрящевой пластинке века. Названы эти железы в честь открывшего их профессора Мейбома, и относятся они к группе сальных. Их секрет участвует в формировании липидного слоя слезной пленки, выстилающей поверхность глазного яблока и внутреннюю часть век.

Симптомы внутреннего ячменя
Начальные симптомы внутреннего и наружного ячменя схожи: больного преследуют боль, отек, повышенное слезотечение, ощущение чужеродного тела. На внутренней стороне века можно заметить гиперемированный участок с желтоватой серединкой. Внутренний ячмень обычно болезненней внешнего, и времени для его созревания требуется больше.
Созревший внутренний ячмень вскрывается в конъюнктивальный мешок. При неблагоприятном течении заболевания на месте ячменя может образоваться халязион — хроническое воспаление участка хряща и железы, при котором проток железы закупоривается, и секрет не может выйти наружу. Выглядит халязион как плотный гиперемированный шарик размером от просяного зерна до горошины. Это состояние требует обязательного лечения под контролем офтальмолога.
В редких случаях образование ячменя — как внутреннего, так и внешнего — может сопровождаться общим недомоганием, повышением температуры, ломотой в суставах, мышечной и головной болью, увеличением лимфатических узлов, расположенных рядом с пораженным глазом. Обычно такая реакция организма говорит об осложненном течении заболевания. Обратитесь к врачу: возможно, потребуется более серьезное лечение ячменя или дополнительная диагностика.
1.Что такое ячмень и халязион и причины возникновения
Ячмень и халязион выглядят как бугорки, расположенные по краям век. Они могут быть болезненными и вызывать раздражение, но редко бывают действительно серьезной проблемой. В большинстве случаев ячмень и халязион исчезают сами по себе.
Ячмень на глазу – это инфекция, которая вызывает появление красноватого шишкообразного бугорка на веке. Как правило, ячмень образуется вдоль краев век. Но иногда ячмень может появляться и внутри века – т.н. внутренний ячмень.
Халязион – это комочек на веке. Халязион может выглядеть как ячмень на глазу, но обычно он имеет больший размер и не вызывает болезненных ощущений.
Появление ячменя и халязиона может быть связано с блефаритом – заболеванием, при котором воспаляются веки. Причины ячменя и халязиона.
Ячмень на глазу появляется из-за бактериальной инфекции. Обычно бактерии попадают в основание ресницы у самого века и вызывают рост ячменя. Внутренний ячмень появляется, когда происходит инфицирование крошеных сальных желез внутри века.
Халязион образуется, когда блокируется сальная железа на веке. Если внутренний ячмень не лечить, он может перерасти в халязион.
Причины появления и факторы риска
Для понимания возможных причин появления на глазу ячменя ключевым моментом является то, что ячмень – это всегда инфекция. Дальнейшую статистику можно бы изложить так: практически всегда это бактериальная инфекция, в подавляющем большинстве таких случаев – стафилококковая, где почти в 100% случаев возбудителем является Staphylococcus aureus, или золотистый стафилококк.
Возвращаясь к более строгой лексике, гордеолум следует определить как острый гнойный инфекционно-воспалительный процесс, вызванный попаданием и бурным размножением возбудителя в ресничном фолликуле, потовой или сальной железе (как правило, в железах Цейса). Отсюда преимущественные пути заражения и наиболее предрасположенные к ячменям категории населения:
- дети с недостаточными санитарно-гигиеническими навыками;
- злоупотребляющие макияжем женщины (особенно те, кто пренебрегает требованиями строгой индивидуальности инструментария и достаточного качества косметики);
- лица со сниженным иммунитетом (например, ослабленные хроническим соматическим заболеванием, операцией, авитаминозом, недоеданием и пр.);
- пациенты, страдающие эндокринными и/или гастроэнтерологическими расстройствами, сезонными аллергиями и т.п.
Во многих источниках в качестве факторов риска указываются также переохлаждение, наличие других воспалительных очагов и процессов в глазу (например, блефароконъюнктивита), наследственная предрасположенность, патогенная активность паразитирующего на коже микроскопического клеща Демодекс.
Как быстро вылечить ячмень на глазу
Лечение включает в себя народные и медикаментозные средства, которые помогают быстрее выйти гною и избавиться от воспаления.
В это время не рекомендуется пользоваться декоративной косметикой (тенями, подводкой, карандашом) и носить контактные линзы.
Лечение в домашних условиях
В большинстве случаев воспаление лечится в домашних условиях, однако если наружная форма запущена, потребуется хирургическое вмешательство. Вскрытие гнойника и обработка антисептиками необходимы при воспалении на внутренней поверхности века. Лечить незапущенный ячмень на глазу следует антибактериальными мазями и каплями, сухим теплом, компрессами и витаминами.

В лечении ячменя на глазу применяются капли с антибактериальным эффектом
Нельзя удалять «бугорок» механическими методами, пытаясь выдавить гной. На начальной стадии участок следует обработать зеленкой, йодом или наложить спиртовой компресс (ватка, смоченная в водке)
Особое внимание на процесс следует обратить при множественном воспалении. В этом случае необходимо обратиться к окулисту
Медикаментозные средства от ячменя на глазу
На начальной стадии может помочь обработка пораженного участка зеленкой, физиотерапевтические процедуры: электрофорез с антибиотиками, УВЧ, прогревания. Обязательно нужно закладывать за веко мазь или смазывать ею нужный участок. Эффективные мази: однопроцентная тетрациклиновая, гидрокортизоновая, «Гентамицин», «Левомеколь», «Эритромицин».

Лечение должно включать в себя использование капель с антибактериальным эффектом. Отличаются результативностью: «Флоксал», «Ципромед», «Альбуцид», «Софрадекс», «Левомицетин», «Тобрекс».

Консервативная терапия помогает быстро избавиться от проблемы без опасности возникновения осложнений и побочных эффектов.
Народные средства от ячменя
Народные методы менее эффективны по сравнению с медикаментозными, но на начальных этапах развития болезни помогают остановить развитие воспалительного процесса.

Черный чай, отвар из ромашки и сок алоэ помогают избавиться от ячменя на глазу
Советы наших бабушек:
- Одно из проверенных средств – прикладывание ватных дисков, пропитанных заваркой черного чая.
- При склонности к образованию ячменей рекомендуется делать отвары и настои из пижмы.
- Хорошо помогает бороться с воспалительным процессом сваренное вкрутую яйцо. Его следует обернуть мягкой тканью и прикладывать к глазу, пока яйцо не остынет.
- На закрытый глаз можно накладывать маленький кусочек ваты с одной каплей спирта или водки. Держать такой компресс следует около 30 мин.
- Бороться с воспалением помогает сок алоэ, отвар фенхеля или ромашки, а также настой из зверобоя, календулы с добавлением прополиса.
Помните, что место воспаления нельзя греть, если уже появился гнойный «бугорок».
Лечение каплями
Лечить ячмень на веке при помощи капель – эффективный способ, так как данное заболевание вызвано инфекцией. Это консервативный способ лечения, который может быть и не таким быстрым, как использование мазей, но зато дает стопроцентный результат.
Важно! Все мази, используемые в данном случае – антибиотические препараты, перед применением которых необходимо посоветоваться с лечащим врачом.
Серди препаратов, используемых для лечения данного офтальмологического заболевания, популярностью пользуются:
- Альбуцид. Несмотря на то, что это лекарство со временем вытесняется с фармакологического рынка более действенными современными аналогами, эти капли все еще остаются одним из самых недорогих и безопасных средств для лечения ряда инфекционных офтальмологических заболеваний. Тем не менее, альбуцид имеет ряд побочных эффектов, а при применении может вызывать зуд, жжение и дискомфортные ощущения.
- Торбекс. Современная альтернатива альбуциду. Такие капли точечно действуют на очаг воспаления, поражая инфекцию и ускоряя процесс рассасывания гнойника. Единственный минус такого препарата в том, что он может быть малоэффективен при лечении группы гнойников.
- Гентамицин. Щадящие антибиотические капли, которые могут назначаться в тяжелых случаях или при ячменях, которые не удалось устранить с помощью тобрекса.
Почему происходит закупорка железы
Халязион — одна из трех наиболее распространенных доброкачественных опухолей век3. Чаще образуются только папилломы и кисты. Проблема чаще всего возникает у детей и в уже зрелом возрасте — после 35 лет. Детский халязион, как правило, связан с нарушением гигиены, конъюнктивитом, врожденным иммунодефицитом. Но пусть вас в данном случае не пугает слово «опухоль». При правильном лечении избавиться от халязиона можно за 2 недели.
Грязные кисточки для макияжа могут стать причиной появления халязиона. Фото: valuavitaly / Depositphotos
Гормоны и витамины
У взрослых людей повлиять на выделение сального секрета могут проблемы с обменом веществ. Работа мейбомиевых желез включена в сложную систему, которая контролируется половыми гормонами — андрогенами, эстрогенами, прогестинами7. Их функциональность зависит от количества витамина А в организме — сбой может произойти из-за его дефицита. Это же касается и ретиноевой кислоты, которая в организме отвечает за усвоение витамина А.
Эндокринные болезни
Опухоль может развиться и из-за сахарного диабета, других эндокринных нарушений. В этих случаях нарушается обмен веществ в тканях века, что приводит к ухудшению работы желез.
Патологии ЖКТ
В ряде случаев спровоцировать проблему могут болезни пищеварительной системы, нарушающие обмен липидов. Из-за этого секрет мейбомиевых и других сальных желез может менять консистенцию, загустевать и накапливаться в протоках.
Кожные заболевания
Есть также предположение, что причина халязиона — кожные клещи демодекс. Они в норме присутствуют в коже каждого человека, но при значительном снижении иммунитета бесконтрольно размножаются.
Может ли причиной стать кожное заболевание?
Да, такие клинические случаи есть, они связаны чаще всего с себореей и демодекозом. Микроорганизмы и вызванное ими воспаление блокируют протоки желез, из-за чего они постепенно сужаются и могут вообще зарубцеваться. Закупорка железы может быть спровоцирована ячменем, а также акне, розацеа, блефаритом, угревой сыпью.
Частое появление ячменей
В качестве профилактики повторных ячменей необходимо, прежде всего, обследование и устранение патологической почвы, способствующей рецидивам гордеолума: санация очагов хронической инфекции, купирование обострений хронических соматических заболеваний, укрепление общего и локального иммунитета, по возможности – коррекция эндокринного фона, нормализация рациона питания и т.д.
Не стоит пренебрегать обращением к врачу с данным заболеванием. Несмотря на его распространенность и, казалось бы, «безобидность» ячмень может привести к развитию ряда серьезных осложнений (флегмона и абсцесс глазницы, сепсис и другие). Поэтому при первых признаках заболевания обращайтесь в наш офтальмологический центр. Это поможет быстро вылечить ячмень и избежать нежелательных последствий самолечения.
Огромное значение имеет также следование элементарным санитарно-гигиеническим нормам и принципам, которые у любого цивилизованного человека должны с детства приобретать характер осознанной потребности и автоматизированного навыка. Все эти вопросы будут подробно, терпеливо и, если понадобится, неоднократно разъяснены лечащим врачом-офтальмологом
И лишь от пациента зависит, – как воспользоваться этой несложной, но очень важной информацией





































